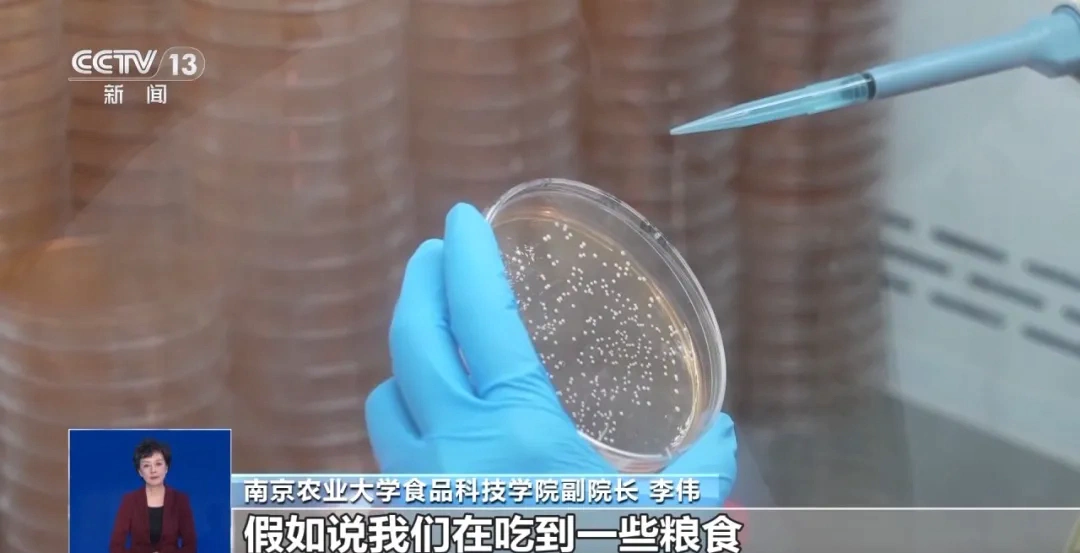

近日,网上流传出一则视频,声称冷冻馒头不能吃了,因为冷冻超过两天会长出毒性堪比“砒霜”的黄曲霉素!那么,馒头冻上两天真的会长黄曲霉素吗?冻馒头真的是成了“致癌餐”了?接下来一起还原事实,洞悉真相。
冷冻环境不适宜黄曲霉毒素的生长
馒头冷冻两天真的会长黄曲霉素吗?就此问题,记者采访了南京农业大学的相关专业人员。
南京农业大学食品科技学院副院长 李伟:黄曲霉毒素是黄曲霉菌产生的次生代谢产物,一种毒素。
专家介绍,通常食物的温度和湿度要达到一定的条件,才会产生黄曲霉素,冷冻或冷藏的环境都不适宜黄曲霉素的生长。

南京农业大学食品科技学院副院长 李伟:冷冻的条件是非常不适合黄曲霉菌生长代谢,或者产生毒素的条件。如果要产生黄曲霉毒素,一般要满足几个条件,第一要有比较适宜的温度,通常霉菌适宜的温度从15℃到35℃,是它比较适合生长的温度。另外霉菌的生长需要有湿度,湿度也是比较高的,80%到90%的湿度。

据了解,一般家用冰箱的冷冻温度在零下18℃,湿度也相对较低。因此,并不满足黄曲霉菌产生毒素的条件。对此,专家辟谣表示,这种说法过分夸大了冷冻馒头可能的风险。
浙大回应网传短视频:没有相关研究
网上流传的这个视频据称来自——浙大研究发现,那么,这是不是浙大研究团队的科研结果呢?近日总台记者采访了浙江大学生物系统工程与食品科学学院副院长刘东红。
浙江大学生物系统工程与食品科学学院副院长 刘东红:浙江大学一直非常关注食品安全领域的研究工作,也非常关心微生物导致的致病性食用菌的安全的研究工作,但是浙江大学没有做过冷冻馒头产生黄曲霉毒素的研究。因为我看到网上一年前也有过类似的报道,还有更早的时候也有。这些报道都打着不同学校的名义,显然说明报道是不真实的。
如何防范霉素风险?面食如何正确保存?
黄曲霉素的主要来源是哪儿?该如何防范?

南京农业大学食品科技学院副院长 李伟:对于黄曲霉菌,它也有一些非常喜欢的宿主,特别是玉米和花生。霉菌长了毒素以后,因为它有基内的菌丝,实际上菌丝或者毒素不仅可以深入食品的表面,还会深入内部。因为有的时候无法从颜色上观察菌丝渗透深浅。
南京农业大学食品科技学院副院长 李伟:一般情况下,如果品尝到粮食或者花生有异味,这个时候不要仅仅把这个东西吐掉,而且还要用水大量涮口腔,我们吃到的苦味都和一些毒素的产生或者不好的物质有密切关系。
新鲜的馒头或者面食没有吃完,应该如何正确保存?

南京农业大学食品科技学院副院长 李伟:长期存放要放在冷冻的环境,三个月内吃完。如果放在冷藏的条件下,可以拿保鲜膜把它包起来,再把它放在保鲜袋里面。在放之前最好不要用手或者跟周围环境接触太多。
【未经授权,严禁转载!联系电话028-86968276】

谣言止于科学,课代表申请出战:黄曲霉菌喜欢的宿主是花生和玉米,并且冷冻馒头的低温条件不适宜黄曲霉菌的生长。
还是多看这种专业科普,不信谣不传谣,搞得家里老年人也一惊一乍的担忧
长知识了
关注健康饮食很重要!
了解真相!
严厉打击网络传谣,假网络信息。